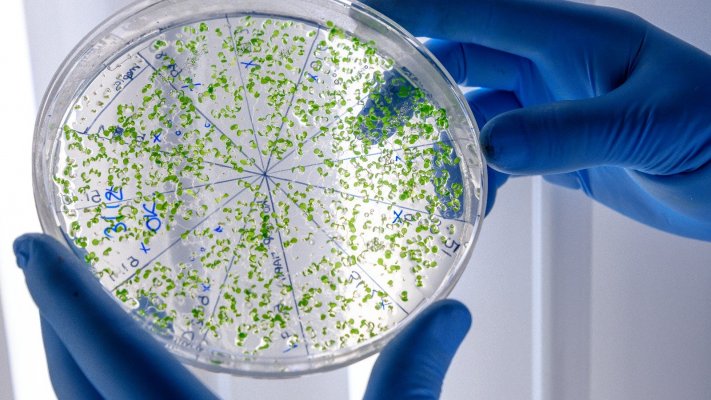

UE alerta para aumento de infeções graves por Listeria na Europa
As alterações nos hábitos alimentares e o envelhecimento da população podem estar a contribuir para o aumento de infeções graves por Listeria na Europa, alertou hoje a União Europeia (UE).
As alterações nos hábitos alimentares e o envelhecimento da população podem estar a contribuir para o aumento de infeções graves por Listeria na Europa, alertou hoje a União Europeia (UE).
De acordo com o novo Relatório de Zoonoses da UE “Uma Só Saúde”, da Autoridade Europeia para a Segurança dos Alimentos (EFSA) e do Centro Europeu de Prevenção e Controlo de Doenças (ECDC), as doenças transmitidas por alimentos continuam a afetar pessoas de todas as faixas etárias, sobretudo os grupos mais vulneráveis.
“Todos os anos, milhares de pessoas adoecem após consumir alimentos contaminados, sendo ovos, carne e produtos prontos a consumir as principais fontes de infeção”, lê-se num comunicado.
Em 2024, a Listeria foi responsável pela maior proporção de hospitalizações e mortes entre todas as infeções alimentares notificadas na UE: cerca de sete em cada dez pessoas infetadas precisaram de cuidados hospitalares e uma em cada 12 morreu.
“Embora a contaminação seja rara, a Listeria pode causar doenças graves, o que a torna uma das ameaças alimentares mais sérias que monitorizamos”, afirmou o chefe da Unidade Única de Doenças Relacionadas com a Saúde do ECDC, Ole Heuer, citado no comunicado.
A tendência crescente de casos nos últimos anos pode estar ligada ao envelhecimento da população, ao aumento do consumo de alimentos prontos a consumir e a práticas inadequadas de conservação.
Apesar de os níveis de contaminação serem baixos, variando entre 0% e 3% das amostras analisadas, são as salsichas fermentadas os produtos mais frequentemente contaminados.
Além da Listeria, outras infeções como Campylobacter e Salmonella continuam a ser as mais comuns na Europa, com a carne de aves e os ovos entre as principais fontes de infeção.
Dados recentes do setor animal mostram um aumento significativo de galinhas reprodutoras e lotes de perus positivos para Salmonella na última década.
Em 2025, apenas 14 Estados-membros da UE cumpriram integralmente as metas de redução da bactéria nas aves.
Em novembro, EFSA pediu aos países da UE que reforçassem as medidas de segurança contra a gripe das aves, após novos alertas de surtos.
Entre 6 de setembro e 14 de novembro, foram registados 1.443 focos de gripe aviária em aves selvagens em 26 países da UE, o número mais elevado desde pelo menos 2016, segundo dados oficiais.
A EFSA apelou ao reforço da vigilância e à adoção de medidas de biossegurança para conter a propagação da doença.
Em Portugal, estão confirmados 44 focos ativos e a Direção-Geral de Alimentação e Veterinária (DGAV) tem vindo a alertar para o risco elevado de disseminação, recomendando medidas adicionais de prevenção.
A transmissão do vírus para humanos é rara, com casos esporádicos reportados em diferentes regiões do mundo. Contudo, quando ocorre, a infeção pode levar a um quadro clínico grave.
“O controlo das bactérias transmitidas por alimentos ao longo da cadeia alimentar exige esforço contínuo e coordenação entre setores”, destacou o chefe da Unidade de Riscos Biológicos e Saúde e Bem-Estar Animal da EFSA, Frank Verdonck.
As autoridades sublinham que a “maioria das doenças transmitidas por alimentos é evitável” e recomendam práticas de higiene adequadas, como manter o frigorífico a cinco graus Celsius (ºC) ou menos, consumir alimentos antes do prazo de validade, cozinhar bem carne e aves, lavar mãos e utensílios após manusear produtos crus e separar alimentos cozinhados dos crus.
Grupos vulneráveis, como idosos, grávidas e pessoas com imunidade debilitada, devem evitar alimentos de maior risco, “como produtos prontos a consumir, leite não pasteurizado e queijos de pasta mole feitos com o mesmo”.
O Relatório de Zoonoses “Uma Só Saúde” reúne informações de todos os Estados-membros da UE e de 11 países não pertencentes à UE, numa abordagem integrada que reconhece as ligações entre saúde humana, animal e ambiente.

Governo dos Açores disponível para reforçar informação sobre Serviço Regional de Saúde

Centro de Informação Antivenenos atendeu 27.275 chamadas no ano passado

Adolescentes cujos pais se distraem mais com os telemóveis são mais inseguros

Maioria do continente com concentrações moderadas a elevadas de pólen na atmosfera

Governo atribui quatro milhões a aproveitamento de plasma para medicamentos

Ébola: Número de mortos na RDCongo eleva-se para 202 - União Africana

Província moçambicana de Nampula com 155 casos de sarampo e uma morte em cinco meses

Ébola: União Africana mobiliza 793 ME para acelerar resposta à epidemia

Ordem critica exclusão dos enfermeiros de grupos trabalho e culpa Direção Executiva

Empresários sugerem criação de Portal da Transparência da Saúde dos Açores

Gripe A detetada em doentes e profissionais de saúde em hospital no Funchal
